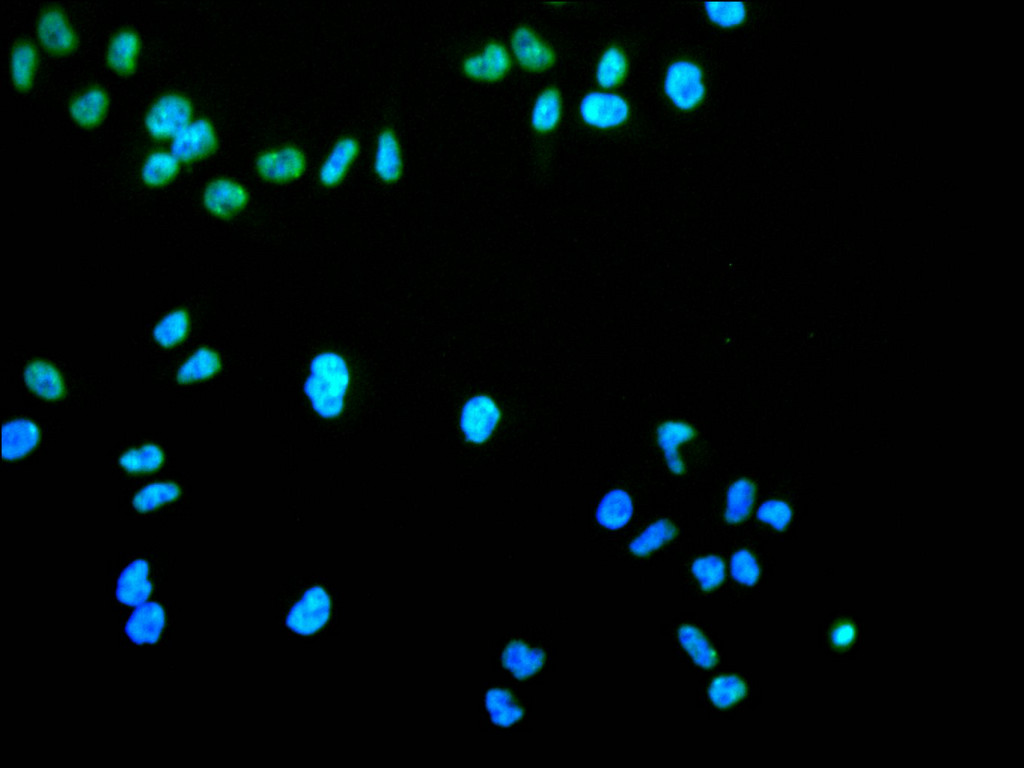

-
中文名稱:KHDRBS1 Recombinant Monoclonal Antibody
-
貨號:CSB-RA130887A0HU
-
規格:¥1320
-
圖片:
-
Western Blot
, Positive WB detected in:A549 whole cell lysate(30μg), COLO205 whole cell lysate(30μg), HEK293 whole cell lysate(30μg), Mouse brain tissue lysate(30μg), Rat brain lysate(30μg)
All lanes: KHDRBS1 antibody at 1:1000
Secondary
Goat polyclonal to rabbit IgG at 1/40000 dilution
Predicted band size: 48 kDa
Observed band size: 68 kDa
Exposure time:20s -
IHC image of CSB-RA130887A0HU diluted at 1:100 and staining in paraffin-embedded human stomach tissue performed on a Leica BondTM system. After dewaxing and hydration, antigen retrieval was mediated by high pressure in a citrate buffer (pH 6.0). Section was blocked with 10% normal goat serum 30min at RT. Then primary antibody (1% BSA) was incubated at 4°C overnight. The primary is detected by a Goat anti-rabbit polymer IgG labeled by HRP and visualized using 0.05% DAB.
-
IHC image of CSB-RA130887A0HU diluted at 1:100 and staining in paraffin-embedded human prostate cancer performed on a Leica BondTM system. After dewaxing and hydration, antigen retrieval was mediated by high pressure in a citrate buffer (pH 6.0). Section was blocked with 10% normal goat serum 30min at RT. Then primary antibody (1% BSA) was incubated at 4°C overnight. The primary is detected by a Goat anti-rabbit polymer IgG labeled by HRP and visualized using 0.05% DAB.
-
Immunofluorescence staining of HeLa cell with CSB-RA130887A0HU at 1:50 , counter-stained with DAPI. The cells were fixed in 4% formaldehyde, permeabilized using 0.2% Triton X-100 and blocked in 10% normal Goat Serum. The cells were then incubated with the antibody overnight at 4°C. The secondary antibody was Alexa Fluor 488-congugated AffiniPure Goat Anti-Rabbit IgG(H+L).
-
Overlay Peak curve showing Hela cells stained with CSB-RA130887A0HU (red line) at 1:100. The cells were fixed in 4% formaldehyde and permeated by 0.2% TritonX-100 for 10min. Then 10% normal goat serum to block non-specific protein-protein interactions followed by the antibody (1ug/1*106cells) for 45min at 4℃. The secondary antibody used was FITC-conjugated goat anti-rabbit IgG (H+L) at 1/200 dilution for 35min at 4℃.Control antibody (green line) was Rabbit IgG (1ug/1*106cells) used under the same conditions. Acquisition of >10, 000 events was performed.
-
-
其他:
產品詳情
-
Uniprot No.:
-
基因名:KHDRBS1
-
別名:FLJ34027 antibody; GAP associated tyrosine phosphoprotein p62 antibody; GAP-associated tyrosine phosphoprotein p62 antibody; KH domain containing RNA binding signal transduction associated 1 antibody; KH domain-containing antibody; KHDR1_HUMAN antibody; Khdrbs1 antibody; p21 Ras GTPase activating protein associated p62 antibody; p21 Ras GTPase-activating protein-associated p62 antibody; p62 antibody; p68 antibody; RNA-binding antibody; Sam68 antibody; signal transduction-associated protein 1 antibody; Src associated in mitosis 68 kDa protein antibody; Src-associated in mitosis 68 kDa protein antibody
-
反應種屬:Human, Mouse, Rat
-
免疫原:A synthesized peptide from human KHDRBS1 protein
-
免疫原種屬:Homo sapiens (Human)
-
標記方式:Non-conjugated
-
克隆類型:Monoclonal
-
抗體亞型:Rabbit IgG
-
純化方式:Affinity-chromatography
-
克隆號:9F10
-
濃度:It differs from different batches. Please contact us to confirm it.
-
保存緩沖液:Rabbit IgG in 10mM phosphate buffered saline , pH 7.4, 150mM sodium chloride, 0.05% BSA, 0.02% sodium azide and 50% glycerol.
-
產品提供形式:Liquid
-
應用范圍:ELISA, WB, IHC, IF, FC
-
推薦稀釋比:
Application Recommended Dilution WB 1:500-1:5000 IHC 1:50-1:200 IF 1:50-1:200 FC 1:50-1:200 -
Protocols:
-
儲存條件:Upon receipt, store at -20°C or -80°C. Avoid repeated freeze.
-
貨期:Basically, we can dispatch the products out in 1-3 working days after receiving your orders. Delivery time maybe differs from different purchasing way or location, please kindly consult your local distributors for specific delivery time.
-
用途:For Research Use Only. Not for use in diagnostic or therapeutic procedures.
相關產品
靶點詳情
-
功能:Recruited and tyrosine phosphorylated by several receptor systems, for example the T-cell, leptin and insulin receptors. Once phosphorylated, functions as an adapter protein in signal transduction cascades by binding to SH2 and SH3 domain-containing proteins. Role in G2-M progression in the cell cycle. Represses CBP-dependent transcriptional activation apparently by competing with other nuclear factors for binding to CBP. Also acts as a putative regulator of mRNA stability and/or translation rates and mediates mRNA nuclear export. Positively regulates the association of constitutive transport element (CTE)-containing mRNA with large polyribosomes and translation initiation. According to some authors, is not involved in the nucleocytoplasmic export of unspliced (CTE)-containing RNA species according to. RNA-binding protein that plays a role in the regulation of alternative splicing and influences mRNA splice site selection and exon inclusion. Binds to RNA containing 5'-[AU]UAA-3' as a bipartite motif spaced by more than 15 nucleotides. Binds poly(A). Can regulate CD44 alternative splicing in a Ras pathway-dependent manner. In cooperation with HNRNPA1 modulates alternative splicing of BCL2L1 by promoting splicing toward isoform Bcl-X(S), and of SMN1. Can regulate alternative splicing of NRXN1 and NRXN3 in the laminin G-like domain 6 containing the evolutionary conserved neurexin alternative spliced segment 4 (AS4) involved in neurexin selective targeting to postsynaptic partners. In a neuronal activity-dependent manner cooperates synergistically with KHDRBS2/SLIM-1 in regulation of NRXN1 exon skipping at AS4. The cooperation with KHDRBS2/SLIM-1 is antagonistic for regulation of NXRN3 alternative splicing at AS4.; Isoform 3, which is expressed in growth-arrested cells only, inhibits S phase.
-
基因功能參考文獻:
- Moreover, SRSF10, hnRNP A1/A2 and Sam68 collaborate to drive the DNA damage-induced splicing response of several transcripts that produce components implicated in apoptosis, cell-cycle control and DNA repair. PMID: 29396485
- SAM68 is required for efficient recruitment of PUM2 to NORAD, regulation of Pum activity by NORAD, and proper chromosome segregation in mammalian cells. PMID: 29386330
- Results revealed that upregulation of Sam68 significantly inhibited cisplatin-induced apoptosis in oral tongue squamous cell carcinoma cells. PMID: 27473117
- The PRMT2 interacts with SAM68 in cells and regulates its subcellular localization via the SH3 domain of PRMT2, prompting us to investigate the potential role of PRMT2 in BCL-X alternative splicing. PMID: 28057797
- Data suggest that the first 22 bp of exon 3 in BIRC5 contain cis-acting elements that enhance the exclusion of exon 3 to generate the survivin DEx3 mRNA isoform via exclusion/deletion of exon 3; Sam68 is a possible trans-acting factor that binds to this cis-acting element and regulates exon 3 splicing. (BIRC5/survivin = baculoviral IAP repeat containing 5; Sam68 = GAP-associated tyrosine phosphoprotein p62) PMID: 28655776
- our results indicated that Sam68 modulates apoptosis of intestinal epithelial cells via mediating NF-kappaB activation in ulcerative colitis PMID: 27235792
- Sam68 possibly participated in the progresses of T-acute lymphoblastic leukemia at least partially via AKT/mTOR signaling pathway PMID: 27107742
- Sam68 is essential for DNA damage-induced NF-kappaB activation and colon tumorigenesis. PMID: 27458801
- These findings define a hitherto novel mechanism of action for Sam68 in governing p53 transcriptional activation, and represent the first report of Sam68 in the regulation of tumor suppressor activities. PMID: 27365047
- HNRNPL acts as the adaptor to combine the two substructures and form the intact Sam68 nuclear body through the interaction of two sets of RNA recognition motifs with the putative architectural RNA in the respective substructures. PMID: 27377249
- Sam68 was overexpressed in EOC tissue in association with such cancer malignant factors of FIGO stage, histological grade, and lymph node metastasis, and also positively regulated the proliferation of EOC cells. PMID: 27623016
- Taken together, these results illuminated that enterovirus 71 infections can induce stress granule formation, and Sam68, as a stress granule component, migrates alone with stress granules dependent on intact microtubule upon the viral infections. PMID: 27057671
- The host factor Sam68 interact with both, foot-and-mouth disease virus RNA motifs in the internal ribosome binding site and viral non-structural proteins 3C(pro) and 3D(pol). PMID: 26695943
- Sam68 has separable effects on the regulation of AR-V7 expression and transcriptional activity, through its RNA-binding capacity. PMID: 26310125
- The RNA-binding protein Sam68 regulates tumor cell viability and hepatic carcinogenesis by inhibiting the transcriptional activity of FOXOs PMID: 26438629
- Sam68 Promotes NF-kappaB Activation and Apoptosis Signaling in Articular Chondrocytes during Osteoarthritis PMID: 26350037
- MicroRNA-203 inhibits the malignant progression of neuroblastoma by targeting Sam68. PMID: 26136151
- Here we review recent studies on the role of SAM68 in splicing regulation and we discuss its contribution to aberrant pre-mRNA processing in cancer. [review] PMID: 26273626
- Sam68 could promote esophageal squamous cell carcinoma(ESCC) cell proliferation via the activation of Akt/GSK-3beta pathway. This research indicated that Sam68 might accelerate the cell cycle progression and be considered as a new therapy target in ESCC PMID: 26050229
- Results show that SAM68 expression is increased in muscle invasive bladder cancer (MIBC) and correlated with poor prognosis suggesting it as a potentially useful prognostic marker for MIBC. PMID: 25944080
- Conclusively, the cleavage of Sam68 is a new indicator for the cell damaging effects of ionizing radiation. PMID: 25666188
- The nuclear protein Sam68 is found as an additional new host factor that interacts with the enterovirus 71 IRES during infection and could potentially enhance the translation of virus protein. PMID: 26202240
- results reveal the complex molecular mechanism underlying SMAR1-mediated signal-dependent and -independent regulation of alternative splicing via Sam68 deacetylation PMID: 26080397
- Sam68 may be useful prognostic marker for EC, and it plays an important role in promoting the cellular proliferation. PMID: 25874492
- The expression of Sam68 was significantly elevated in non-small cell lung carcinoma tissues as compared with adjacent non-cancerous tissues. PMID: 24522888
- This study provides evidence that both high expression level and nuclear localization of Sam68 correlate with invasiveness and aggressiveness characteristics in coloretal cancer, and poorer survival. PMID: 23937454
- Sam68 is a role in the regulation of differential expression and mRNA processing and translation according to internal and external signals. PMID: 24287914
- FBI-1 affects recruitment of SAM68 on the BCL-X transcript through an HDAC dependent mechanism. PMID: 24514149
- These data, plus the fact that Sam68 is known to be a signaling adaptor protein, indicated that Sam68 is a signal molecule with a functional role in the PI3K/Akt signal pathway during enterovirus 71 infection. PMID: 24316008
- Deficient SAM68 expression was observed in the human testis with maturation arrest at the spermatocyte stage and Sertoli cell-only syndrome. PMID: 24794312
- Sam68 is identified as a novel non-Rel component in the nuclear factor-kappaB (NF-kappaB) complex that confers CD25 transcription. PMID: 23715268
- Emerging roles for Sam68 in adipogenesis and neuronal development. PMID: 23018781
- Study propose that Sam68 functions as a classical scaffold protein in this context, assembling components of an osteoclast-specific signalling pathway. PMID: 22745667
- Sam68 could induce cervical cancer lymph node metastasis through regulating epithelial-mesenchymal transition PMID: 21700735
- The results show that DDX3, eIF5A, and hRIP enhanced HIV-1 internal ribosomal entry site-mediated translation, whereas Sam68 does not. PMID: 21360055
- The tyrosine-rich domain of Sam68 is bound in a bent conformation to the APC groove. PMID: 22000517
- Sam68 interacts with insulin receptor substrate (IRS)-1 in basal conditions, and insulin increases the affinity between these two partners. PMID: 22005517
- Sam68 is required for both NF-kappaB activation and apoptosis signaling by the TNF receptor PMID: 21620750
- High Sam68 expression is associated with pancreatic cancer progression. PMID: 21642356
- These results demonstrated for the first time that Hsp22 regulates Sam68 expression and the ratio of Sam68 to Hsp22 may determine the proliferative potential of glioblastoma cells. PMID: 21678403
- Met receptors induce Sam68-dependent cell migration by activation of alternate extracellular signal-regulated kinase family members PMID: 21489997
- These results strongly suggest the participation of Sam68 in leptin receptor signaling in human trophoblastic cells, and therefore, Sam68 may mediate some of the leptin effects in placenta. PMID: 21035519
- Sam68 modulation of SF2/ASF splicing is controlled by epithelial cell-derived soluble factors that act through the ERK1/2 signaling pathway to regulate Sam68 phosphorylation. PMID: 20876280
- the Qua1 homodimerization domain is required for regulation of alternative splicing by Sam68. PMID: 20610388
- Sam68 is sequestered by expanded CGG repeats and thereby loses its splicing-regulatory function. PMID: 20186122
- In vivo splicing assays showed that Sam68 triggers SMN2 exon-7 skipping. PMID: 20186123
- SAM68 could represent a novel and useful prognostic marker for renal cell carcinoma. High SAM68 expression and cytoplasmic localization are associated with poor overall survival in renal cell carcinoma patients PMID: 19755649
- Sam68 interacts with HIV-1 Rev protein and directly participates in nuclear exportation of HIV-1 unspliced or singly spliced RNA. PMID: 19535902
- Our results identify Sam68 as the first splicing factor to affect CCND1 alternative splicing in prostate cancer cells PMID: 20028857
- Sam68 is recruited into stress granules through complexing with TIA-1 in response to oxidative stress PMID: 19615357
顯示更多
收起更多
-
亞細胞定位:Nucleus. Cytoplasm. Membrane.
-
蛋白家族:KHDRBS family
-
組織特異性:Ubiquitously expressed in all tissue examined. Isoform 1 is expressed at lower levels in brain, skeletal muscle, and liver whereas isoform 3 is intensified in skeletal muscle and in liver.
-
數據庫鏈接:
Most popular with customers
-
-
YWHAB Recombinant Monoclonal Antibody
Applications: ELISA, WB, IHC, IF, FC
Species Reactivity: Human, Mouse, Rat
-
Phospho-YAP1 (S127) Recombinant Monoclonal Antibody
Applications: ELISA, WB, IHC
Species Reactivity: Human
-
-
-
-
-